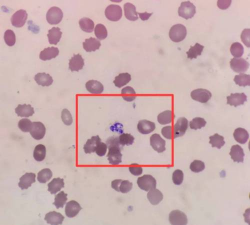
牛粪养花的正确方法，避免烧根，提升肥效

哈密瓜种植时间和方法
哈密瓜是一种很受欢迎的水果,具有清香甜美的口感和丰富的营养成分。在我国,哈密瓜的主要产区是新疆,而且新疆的哈密瓜以其优质、甜度高、口感好而闻名于世。下面。小编将为大家介绍一下哈密瓜种植时间和方法。
哈密瓜种植时间
哈密瓜最好的播种时间是2-5月份和8-10月份,这两个时间段播种的哈密瓜种子发芽率最高,长得最好,出苗时白天要求30度以上温度,夜间需要18-20度。哈密瓜一般在晚霜过后种植,若是用地膜覆盖可在4月20前后种,不采用地膜播种时间就会推后。定植应以秧龄和叶龄为准,春季苗龄30天左右。
哈密瓜的种植方法
1、选址
哈密瓜属于南瓜科植物,喜阳光充足、温暖、干燥、通风良好的环境。因此,选址是种植哈密瓜的关键。一般来说,选取南向坡地或平地,地势略高,排水良好的土地为好。同时,要避免选取低洼地或水涝地。
2、土壤
哈密瓜喜欢生长在肥沃、疏松、透气性好的土壤中,pH值在6.5-7.5之间。因此,在种植哈密瓜前,需要进行土壤改良。通常可以在土地中加入有机肥和矿质肥,如腐熟的鸡粪、牛粪、羊粪、沙子等。同时,还可以在土地中加入磷、钾等元素,以提高土壤的肥力和保水能力。
3、品种选择
哈密瓜的品种很多,不同品种的特点和适应性不同。在选择品种时,应根据自己的实际情况选择。一般来说,新疆的哈密瓜品种有很多,如白兔、早龙、新凤、甜美、金凤等。这些品种既适应新疆的气候环境,又具有较高的产量和品质。
4、播种
哈密瓜的播种时间一般在4月中旬至5月初。在播种前,需要将种子浸泡在温水中,使种子吸水膨胀,提高发芽率。然后将种子均匀撒在培育盘或育苗盆中,覆盖一层薄土,保持土壤湿润,待幼苗长至2-3片真叶时,即可移栽到田间。
5、移栽
哈密瓜的移栽一般在5月中旬至6月初进行,当气温达到10℃以上时,可将幼苗移栽到田间。移栽时,需要事先在土地中准备好犁沟,将幼苗放入沟中,覆盖一层薄土,然后浇透水。移栽后,要及时浇水,保持土壤湿润。
6、管理
哈密瓜的管理主要包括浇水、施肥、除草、松土、病虫害防治等方面。在生长期间,要保持土壤湿润,但不要过度浇水,以免影响果实的品质和产量。同时,要定期施肥,以提高哈密瓜的产量和品质。除草和松土可以保持土壤的透气性和肥力,提高哈密瓜的生长速度和产量。病虫害防治则可以保证哈密瓜的品质和产量。
7、采摘
哈密瓜的采摘时间一般在7月中旬至8月中旬。当果实变黄、表皮变薄、果蒂变干时,即可采摘。采摘后,要及时清洗、晾晒,以保持果实的品质和口感。
旱莲什么时候开花
旱莲的开花时间因种类不同而有所差异,主要分为以下两类:播种到开花时间:若春季播种(3-6月),通常需约 3-4个月,花期集中在 8-12月;若秋季播种(8-9月),则可在元旦或春节期间开花。花期持续时间:单朵花可持续 7-10天,整体花期因
· 2025-11-05

玉珠帘为什么会开花
玉珠帘开花的原因与其生物学特性和生长环境密切相关,具体可归纳为以下四点:植物学特性驱动开花玉珠帘属于景天科景天属多肉植物,其花朵由顶生茎端的伞房花序发育而来。伞房花序是一种聚伞状花序,通常由多个小花组成,颜色多为深紫红色或玫瑰红色。这种花序
· 2025-11-05

马的血液寄生虫
血液寄生虫是生活在动物宿主血液中的生物体。这些寄生虫的范围从单细胞原生动物到更复杂的细菌和立克次体。传播方式因寄生虫而异,但通常是通过蜱虫或苍蝇的叮咬传播的。巴贝西虫病巴贝斯虫病是一种由蜱传播的疾病。它影响各种各样的家畜和野生动物,偶尔也影
· 2025-11-05

河北葡萄怎么种植
河北葡萄种植与管理需结合当地气候条件,重点关注底肥施用、病虫害防治及生长周期管理。以下是具体建议:选址与土壤 选择阳光充足、排水良好的沙壤土,pH值控制在5.5-7.0之间。深耕后施足基肥,每亩有机肥2000-3000公斤(如羊粪、堆肥)
· 2025-11-05

矮子草花有哪些
矮草花品种丰富,主要分为多年生和一年生两类,以下是常见品种及特点:石竹高度:30-50厘米 特点:花色丰富(红、紫、白等),耐旱耐寒,适合花坛边缘或岩石花园装饰。三色堇 高度:10-30厘米 特点:花型小巧,花色多样(紫、蓝、黄),喜
· 2025-11-05

山泥适合养什么花卉
山泥(又称山泥或山土)是一种天然的含腐殖质土壤,因其疏松、透气和酸性特性,特别适合种植喜酸性环境的花卉。以下是适合用山泥种植的花卉及其具体应用方式:杜鹃花:山泥(尤其是黑山泥)是杜鹃花的理想栽培基质,需搭配腐殖土按1:1比例混合,确保pH值
· 2025-11-05

大头菜是什么菜
大头菜又名孔明菜、诸葛菜,在襄阳俗称“咸菜”芥菜,与榨菜一样,都是芥菜的变种。榨菜是茎用芥菜,大头菜是根用芥菜,雪里蕻是叶用芥菜。而芥末调料,是芥菜的种子碾磨成的。大头菜的形态特征株高约1米,地下有肉质块根,通常膨大成球形、扁圆形或长圆形,
· 2025-11-05

大棚西瓜的种植方法和管理技术
大棚西瓜种植是一种精细集约的栽培方式,它不仅能够提前西瓜的上市时间,还能在一定程度上抵御不良气候对西瓜生长的影响。下面,小编将为大家详细介绍大棚西瓜的种植方法与管理技术。大棚西瓜的种植方法1、品种选择大棚西瓜种植一般较露地栽培早,且气候条件
· 2025-11-05

家庭养花施什么肥合适
家里养花施什么肥最好:速效肥 :适用于花卉营养不良时,需快速补充营养。选择时要注意肥效快但持续时间短。控释肥 :含有控制释放机制的肥料,可以长期保证营养供应。外观上可能有膜衣,需注意花根不要触碰。缓释肥 :长效肥料,但不如控释肥长效。通常只
· 2025-11-05

马的红细胞
红细胞的主要功能是将细胞代谢所需的氧气输送到组织。氧分子附着在称为血红蛋白的载体分子上,血红蛋白是红细胞中含铁的蛋白质,使细胞呈红色。氧气从肺部携带,并通过红细胞内的血红蛋白输送到所有身体组织。细胞利用氧气产生身体所需的能量。在这个过程中,
· 2025-11-05